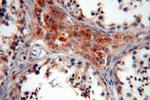
TEKT1 Antibody in Immunohistochemistry (Paraffin) (IHC (P))

Search
Proteintech
TEKT1 Polyclonal Antibody
{{$productOrderCtrl.translations['antibody.pdp.commerceCard.promotion.promotions']}}
{{$productOrderCtrl.translations['antibody.pdp.commerceCard.promotion.viewpromo']}}
{{$productOrderCtrl.translations['antibody.pdp.commerceCard.promotion.promocode']}}: {{promo.promoCode}} {{promo.promoTitle}} {{promo.promoDescription}}. {{$productOrderCtrl.translations['antibody.pdp.commerceCard.promotion.learnmore']}}
产品信息
18968-1-AP
种属反应
已发表种属
宿主/亚型
分类
类型
抗原
偶联物
形式
浓度
规格
纯化类型
保存液
内含物
保存条件
运输条件
产品详细信息
Immunogen sequence: YREKRIGID LVHDTVEHEL IKEAEIIQGI MALLTRTLEE ASEQIRMNRS AKYNLEKDLK DKFVALTIDD ICFSLNNNSP NIRYSENAVR IEPNSVSLED WLDFSSTNVE KADKQRNNSL MLKALVDRIL SQTANDLRKQ CDVVDTAFKN GLKDTKDARD KLADHLAKVM EEIASQEKNI TALEKAILDQ EGPAKVAHTR LETRTHRPNV ELCRDVAQYR LMKEVQEITH NVARLKETLA QAQAELKGLH RRQLALQEEI QVKENTIYID EVLCMQMRKS IPLRDGEDHG VWAGGLRPDA VC (118-418 aa encoded by BC014599)
靶标信息
This gene product belongs to the tektin family of proteins. Tektins comprise a family of filament-forming proteins that are coassembled with tubulins to form ciliary and flagellar microtubules. This gene is predominantly expressed in the testis and in mouse, tektin 1 mRNA was localized to the spermatocytes and round spermatids in the seminiferous tubules, indicating that it may play a role in spermatogenesis.
仅用于科研。不用于诊断过程。未经明确授权不得转售。
生物信息学
蛋白别名: Tektin-1; UG3059e10; unnamed protein product
基因别名: MT14; TEKT1
UniProt ID: (Human) Q969V4, (Rat) Q99JD2, (Mouse) Q9DAJ2
Entrez Gene ID: (Human) 83659, (Rat) 85270, (Mouse) 21689